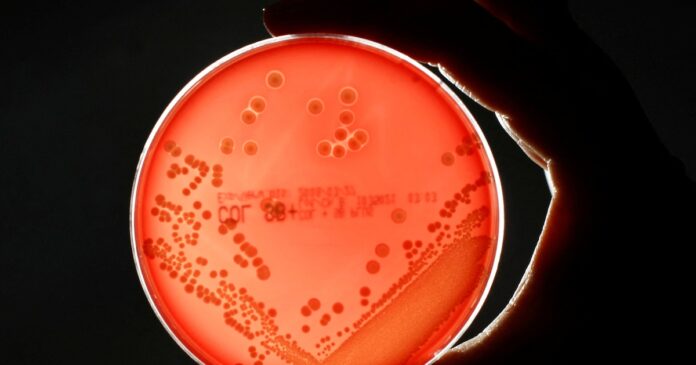

La baceria Staphylococcus aureus resistente a la meticilina (SARM) es responsable de más de 120.000 muertes anuales.
Científicos de Reino Unido e Irlanda encontraron un sistema de división alternativo que refuerza su resistencia a los antibióticos.
Este descubrimiento puede impulsar la búsqueda de fármacos más eficaces, según un estudio publicado en la revista Science.
Lo esencial: un estudio conjunto de las universidades de Sheffield y Dublín descubrió cómo la superbacteria SARM (Staphylococcus aureus resistente a la meticilina) logra resistir antibióticos mediante un doble mecanismo. Además de usar una enzima especial en su pared celular, la bacteria emplea un sistema de división alternativo que le permite replicarse pese a la presencia de estos medicamentos. El hallazgo abre nuevas oportunidades para crear antibióticos más efectivos en un contexto global donde la resistencia a los antimicrobianos es un desafío crítico.
Por qué importa: la resistencia a los antibióticos compromete tratamientos de infecciones y amenaza la salud global.
La superbacteria SARM se destaca por su capacidad de resistir múltiples antibióticos/NIH
Entre las superbacterias que amenazan a la humanidad, el Staphylococcus aureus resistente a la meticilina (SARM) se destaca. Es un tipo de estafilococo que puede ser resistente a varios antibióticos y causa más de 120.000 muertes al año en el mundo.
Biólogos y físicos de la Universidad de Sheffield en el Reino Unido y del Colegio Universitario de Dublín, en Irlanda descubrieron cuál es el mecanismo que permite a esa superbacteria hacerse muy resistente a los antibióticos.
El trabajo fue publicado en la revista Science y sus resultados abren nuevas posibilidades para controlar mejor las enfermedades infecciosas, en un contexto en que existe una necesidad urgente de contar con antibióticos más eficaces y aún no hay vacunas específicas disponibles contra SARM.
Qué es la superbacteria SARM y cuáles son los síntomas
Las infecciones por SARM causan más de 120.000 muertes anualmente (Crédito: NIH)
“El SARM es un tipo de estafilococo que puede ser resistente a varios antibióticos”, según explicaron expertos de los Centros para el Control y la Prevención de Enfermedades (CDC) de los Estados Unidos.
Cualquier persona puede contraer una infección o ser portadora de SARM. El riesgo aumenta en las personas hospitalizadas o que permanecen en residencias de personas mayores, en contacto directo con otras personas (como en los deportes de contacto) y en la exposición a lugares concurridos y poco higiénicos.
Los síntomas de una infección por S. aureus, incluido SARM, dependen de la parte del cuerpo que esté infectada. La piel lesionada, como rasguños o cortes, suele ser el lugar donde se produce la infección por SARM.
La mayoría de las infecciones cutáneas por S. aureus, incluido el SARM, aparecen como un bulto o una zona infectada en la piel que puede ser roja, hinchada, dolorosa, caliente al tacto, llena de pus u otra secreción, acompañada de fiebre.
Qué se descubrió sobre la superbacteria
(Imagen Ilustrativa Infobae)
Los investigadores descubrieron que la superbacteria SARM posee un doble mecanismo de defensa frente a los antibióticos. El hallazgo fue liderado por científicos de la Universidad de Sheffield. Fue financiada por Wellcome y UKRI, que es la agencia pública que apoya la investigación y la innovación en el Reino Unido.
Como otras bacterias, SARM tiene paredes celulares en forma de malla que necesitan enzimas para unirse. Estas enzimas son el objetivo de antibióticos como la penicilina y la meticilina. Este tipo de antibióticos ha salvado millones de vidas durante décadas.
Desde hace muchos años se sabe que, para ser resistente, SARM ha adquirido una nueva enzima de la pared celular que le permite sobrevivir a la exposición a los antibióticos. Sin embargo, los investigadores de Sheffield encontraron que eso por sí solo es insuficiente para que el microorganismo sobreviva.
Demostraron que la superbacteria desarrolló un mecanismo de división alternativo que le permite replicarse en presencia de antibióticos. Este mecanismo es esencial para la resistencia de SARM.
Las personas hospitalizadas tienen mayor riesgo de infección por SARM/ REUTERS/Fabrizio Bensch
Al conocer los detalles de este proceso, los investigadores están trabajando en el desarrollo de inhibidores que puedan atacar la novedosa estrategia de supervivencia del SARM.
“Esta investigación es muy interesante, ya que no sólo ha descubierto un nuevo mecanismo del SARM, que estaba oculto a plena vista, sino también la capacidad de la bacteria para dividirse de forma alternativa”, afirmó Simon Foster, de la Escuela de Biociencias de la Universidad de Sheffield.
Además, agregó: “Estos hallazgos tienen importantes implicancias para el desarrollo de nuevos antibióticos, pero también para comprender los principios fundamentales que sustentan el crecimiento y la división bacterianos. Esto proporcionará nuevas formas de hacer frente a este peligroso organismo infeccioso”.
El equipo de investigadores ya piensa en el próximo paso. Intentarán determinar cómo SARM es capaz de crecer y dividirse en presencia de antibióticos al usar el nuevo mecanismo descubierto.
Qué implican los resultados publicados en Science
El estudio sobre SARM señala el potencial de los antibióticos antiguos (Getty)
Los antibióticos pasaron a ser una piedra angular de la medicina moderna. Como consecuencia, la resistencia a los antibióticos es una amenaza seria para la salud pública en el tratamiento de infecciones bacterianas. Es parte del problema global conocido como “resistencia a los antimicrobianos” o RAM (porque también hay resistencia en antivirales y en productos contra hongos).
De acuerdo con el microbiólogo británico Ewan Harrinson, que escribió otro artículo como perspectiva en Science, poco después de que la penicilina se empezara a usar clínicamente para tratar el Staphylococcus aureus surgieron cepas resistentes al fármaco.
En 1959, se introdujo el antibiótico meticilina para tratar las cepas de S. aureus resistentes a la penicilina. La meticilina es miembro de la familia de los antibióticos betalactámicos, que son ampliamente efectivos contra muchos tipos de bacterias. Pero para 1960 ya se habían reportado infecciones con S. aureus resistente a la meticilina (MRSA).
En diálogo con Infobae el doctor Alejandro Vila, quien investiga en la Argentina el tema de la resistencia a los antimicrobianos en el Instituto de Biología de Rosario (IBR), que depende del Conicet, comentó tras leer el estudio: “El mecanismo de resistencia de la bacteria Staphylococcus aureus al antibiótico meticilina se conoce desde hace 40 años y se debe a una proteína que evade la acción del antibiótico”.
Según los registros, las personas que murieron por dengue contaban con comorbilidades (Getty Images)
Esa proteína también desempeña un papel crucial en la división celular, el proceso mediante el cual las bacterias se multiplican. “Este estudio -expresó Vila- permitió descubrir un nuevo mecanismo de división celular en Staphylococcus aureus cuando se le expone a antibióticos, por el cual varias proteínas cambian sus funciones”.
Los cambios en los roles de las proteínas hacen que la bacteria sea más resistente a la meticilina, “pero tienen un costo: la vuelven más vulnerable a antibióticos antiguos, poco utilizados en la actualidad. Esto abre una nueva oportunidad para el tratamiento contra una de las superbacterias”, expresó.
“Más allá de estos avances específicos, el estudio subraya la importancia de realizar un monitoreo continuo de los mecanismos de resistencia antimicrobiana”, enfatizó el investigador Vila.
Fuente: https://www.infobae.com/america/